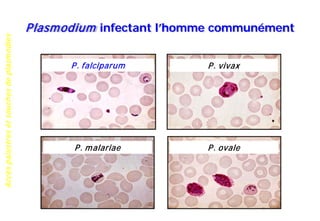
Accèspalustresetsouchesdeplasmodies
Plasmodium infectant l’homme communément
P. falciparum
P. malariae P. ovale
P. vivax

Le document traite du paludisme, une maladie parasitaire curable mais potentiellement mortelle, causée par différentes espèces de Plasmodium, avec un accent sur les groupes vulnérables tels que les femmes enceintes et les jeunes enfants. Il explore également le cycle biologique des parasites, les mécanismes d'immunité acquise, et les défis liés à la résistance au traitement. En conclusion, il souligne la nécessité d'études supplémentaires pour comprendre les facteurs génétiques et immunitaires influençant la gravité de la maladie.